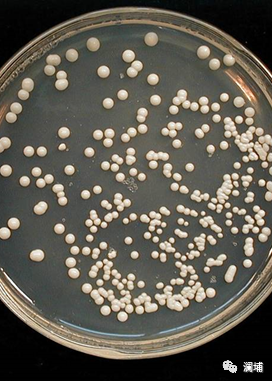
同学,酵母专题课报名进行中 同学,酵母专题课报名进行中

酵母是啤酒的基因。酵母不仅参与啤酒发酵,更影响着啤酒的风味和特点。一款高品质的啤酒不仅需要酿酒师的用心酿造,更需要其具备良好的基因条件,所以也说,酿酒是酿酒师和酵母合力完成的工作。酿酒师必须对酵母有清晰而全面的认知,因为你并不是一个人在#酿酒#~~~

澜埔国际酿酒学院酵母专题课开班啦!
酵母对啤酒质量的影响至关重要
同学,你关心的问题都在这里:
酵母的特性与营养
酵母的选择及使用
酵母的活化、保藏等
酵母的扩培技术及操作
酵母的质量状态检测
酵母对啤酒风味的影响
酿造车间中的使用注意事项
9月13-9月17日,澜埔学院酵母专题课
为你解惑——关于酿造中的酵母那些事儿

#学院新基地,刷新升级中#
学院新基地升级中,将于9月正式投入使用。国内一流的教学硬件设施,多套啤酒酿造设备,分别50L,100L,500L,1000L等不同规格,更配有小型制麦设备、过滤机、离心机、瞬时灭菌机、各种手工灌装机、瓶装灌酒线、易拉罐灌酒线、蒸馏酒设备等,学院实验室可满足酵母扩培、啤酒理化分析与检测等功能。
这是国内目前最完备的啤酒实验生产线,可充分满足培训及科研需求。
课程安排
1.酵母的特性与营养
2.酵母的选择与使用
3.酵母的活化、保藏等
4.酵母的扩培技术及操作
5.酵母的质量状态检测
6.酵母对啤酒风味的影响
7.酿造车间中使用注意事项
课程费用:4500元/人(不含食宿)
课程日期:9月13日-9月17日
咨询电话:132-8776-3383
156-6269-3113

澜埔国际酿酒学院
好好学习,酿好啤酒





